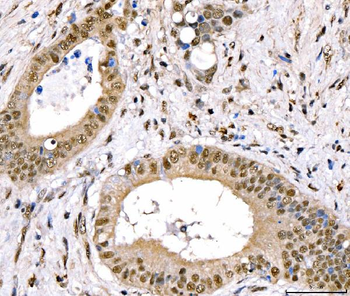
CRTC3 Rabbit Polyclonal Antibody

You have no items in your shopping cart.
All Products
- Glutaminase/GLS Mouse Monoclonal Antibody [orb865661]
FC, ICC, IF, IHC, WB
Human, Mouse, Rat
Mouse
Monoclonal
Unconjugated
100 μg - FACL4/ACSL4 Mouse Monoclonal Antibody [orb865675]
FC, ICC, IF, IHC, WB
Human
Mouse
Monoclonal
Unconjugated
100 μg - RALBP1 Mouse Monoclonal Antibody [orb865681]
FC, ICC, IF, IHC, WB
Human, Mouse, Rat
Mouse
Monoclonal
Unconjugated
100 μg - FABP4 Mouse Monoclonal Antibody [orb865585]
IHC, WB
Human, Mouse, Rat
Mouse
Monoclonal
Unconjugated
100 μg - CRTC3 Rabbit Polyclonal Antibody [orb865494]
ELISA, FC, ICC, IF, IHC, WB
Human, Monkey
Rabbit
Polyclonal
Unconjugated
100 μg - CYB5B Rabbit Polyclonal Antibody [orb865495]
ELISA, FC, ICC, IF, IHC, WB
Human, Mouse
Rabbit
Polyclonal
Unconjugated
100 μg - ECSIT Rabbit Polyclonal Antibody [orb865503]
ELISA, FC, ICC, IF, IHC, WB
Human
Rabbit
Polyclonal
Unconjugated
100 μg - CETP Rabbit Polyclonal Antibody [orb570374]
ELISA, IHC, WB
Human, Mouse, Rat
Rabbit
Polyclonal
Unconjugated
100 μg - DNAJA2 Rabbit Polyclonal Antibody [orb654324]
ELISA, FC, IHC, WB
Human, Mouse, Rat
Rabbit
Polyclonal
Unconjugated
100 μg - Caveolin-2/CAV2 Rabbit Polyclonal Antibody [orb654407]
ELISA, FC, ICC, IF, IHC, WB
Human, Monkey, Mouse, Rat
Rabbit
Polyclonal
Unconjugated
100 μg